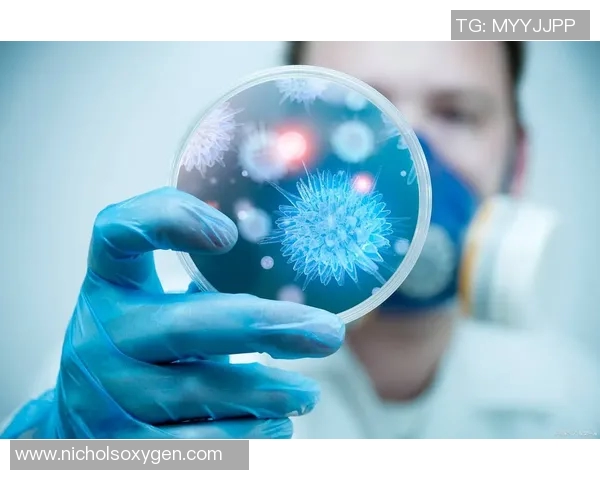
干细胞治疗助力足球明星重返赛场的传奇故事与未来展望

干细胞治疗助力足球明星重返赛场的传奇故事与未来展望
干细胞治疗作为一种前沿的医疗技术,近年来在运动医学领域展现出令人瞩目的潜力。尤其是在足球界,许多因伤退役的明星球员通过这一技术成功恢复,重返赛场,创造了传奇故事。这篇文章将通过四个方面详细探讨干细胞治疗如何助力足球明星重返赛场,包括其基本原理、成功案例分析、对运动员生涯的影响以及未来的发展趋势。通过这些内容,我们可以更深入地理解干细胞治疗在当代体育中的重要性,以及它为运动员带来的希望与可能性。
1、干细胞治疗的基本原理
干细胞是一类具有自我复制和分化能力的特殊细胞,在医学上具有广泛的应用前景。它们能够修复受损的组织和器官,从而在再生医学中发挥重要作用。在运动医学领域,特别是对待运动损伤时,干细胞治疗被认为是一种革命性的技术。
这种疗法主要依赖于从患者自身或其他来源提取的干细胞,通过注射或植入等方式,将其引导到受损部位。这些干细胞能够刺激体内愈合机制,加速组织再生,有效改善关节、肌肉及韧带等部位的功能。
此外,由于干细胞具有较强的免疫调节作用,它们还可以减少术后炎症反应,提高康复效率。因此,越来越多的足球明星选择采用这一疗法,以期尽快恢复竞技状态。
2、成功案例分析
在众多足球明星中,不少人因伤病困扰而面临退役风险,但通过干细胞治疗,他们再次站上了赛场。例如,一位著名前锋在经历严重膝关节损伤后,通过接受干细胞注射,不仅缓解了疼痛,还显著提升了膝关节功能,使得他能顺利回归比赛。
另一位中场球员同样遭遇过类似困境,他曾因长期踢球导致职业生涯早期结束。但经过一系列系统性的治疗,包括物理康复和干细胞疗法,他不仅恢复了健康,还帮助球队赢得了多个荣誉。他们的故事成为激励其他受伤运动员的重要榜样。
这些成功案例不仅展示了干细胞治疗对职业运动员身体恢复的重要性,也让更多人认识到这种技术在现代体育中的应用潜力。随着技术的发展,这些成功经验有望进一步推广到更多运动领域。
3、对运动员生涯的影响
对于许多足球明星而言,受伤往往意味着职业生涯的不确定性。然而,在得到有效治疗后,他们有机会继续追求自己的梦想,这无疑会延长他们的职业生涯。同时,这也给年轻球员传递了一种积极的信息:只要及时采取措施,就有可能战胜伤病带来的挑战。
此外,通过重返赛场,这些球员不仅为自己争取到了新的机会,也为所在球队注入新的活力。他们丰富的比赛经验和卓越技艺,常关键词3常能改变比赛局势,对年轻队友起到良好的示范作用。因此,可以说,干细胞治疗不仅改变了个人命运,也推动了整个团队的发展。
然而,我们也需要注意的是,对于一些极端情况下仍然无法完全治愈的问题,虽然有创新方法存在,但并不意味着每一个受伤者都能顺利复出。因此,在享受科技进步带来的红利时,也需保持合理期待与科学态度。
4、未来的发展趋势
随着科学研究不断深入,我们对干细胞及其应用了解也日益加深,这使得相关技术逐渐成熟。从最初单一类型的干细胞应用,到现在多种类型结合使用,为不同情况提供个性化解决方案,大大提高了临床效果。
未来,我们可以预见的是,随着基因编辑等新兴科技的发展,将会有更多创新型疗法涌现。这些新方法将进一步优化现有疗法,提高安全性与有效性,让更多受到伤病困扰的人群获得帮助。此外,多学科交叉合作也将成为常态,如结合营养学、心理学等领域,共同促进运动员全面康复。
同时,各国间关于这一领域的新研究、新成果分享也将更加频繁,有助于全球范围内推动该技术向更高水平发展。总体来看,未来几乎所有处于竞技状态下的人都将在一定程度上享受到这项先进医疗技术所带来的福利,无论是职业选手还是业余爱好者,都将迎来更加健康、安全、更具竞争力的新纪元。
总结:
综上所述,干细胞治疗作为一种颇具前景的新兴医疗手段,不仅为众多足球明星提供了重返赛场的机会,更为整个体育界树立了一种积极向上的精神象征。成功案例表明,这一技术确实能够有效促进运动员康复,并且延长其职业生涯,为他们继续追寻梦想铺平道路。
展望未来,我们期待着随着科研不断突破,新型疗法不断出现,可以造福更多面临相似困境的人群。同时,希望社会各界能共同关注和支持这项事业,为打造一个更健康、更充满活力的体育环境贡献力量。在这样的背景下,相信我们的足球星光熠熠,将继续书写属于他们的新传奇!









